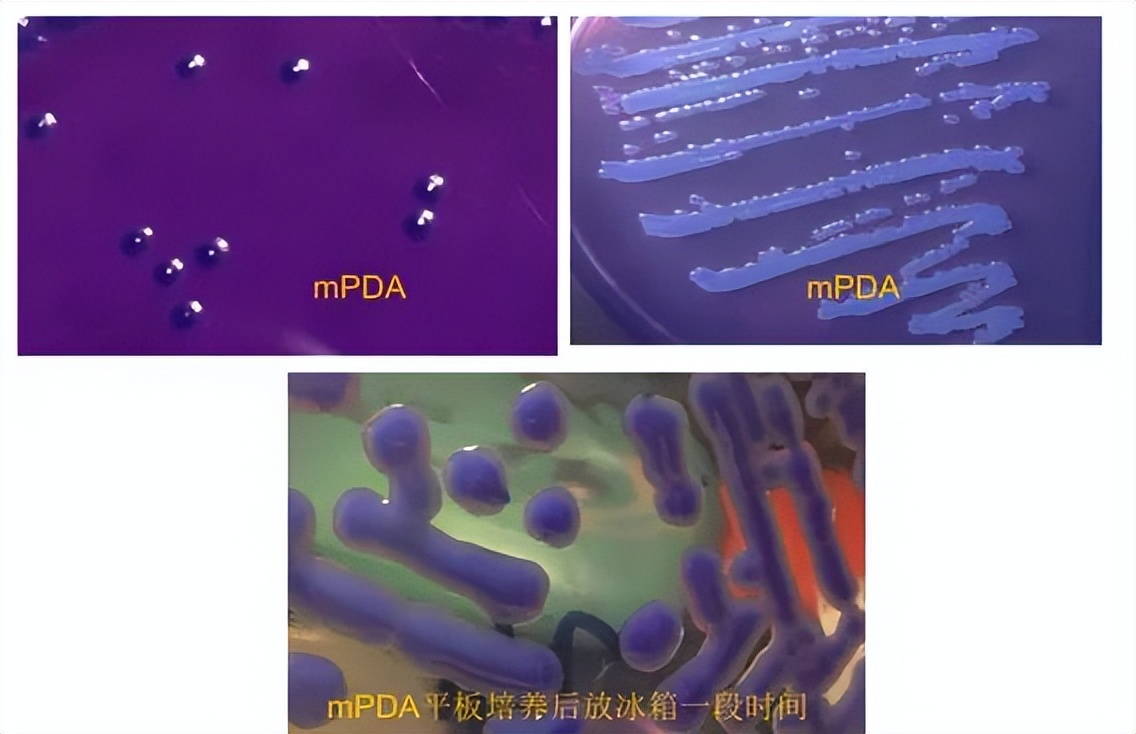
女子吃凉皮中毒是哪家凉皮,吃凉皮中毒会有哪些现状

近日,网上出现多则内容为
河南永城市两名女子 吃凉皮后中毒致1死1伤 的消息
7月15日晚
河南永城市政府网发布情况通告
↓↓↓
近日,网上反映:“永城两女子吃凉皮中毒致一人死亡”“全市的凉皮店都已经查封,暂时不让销售了”。
针对反映的情况,市场监管部门立即对相关凉皮店进行调查,未发现异常情况,永城市域内所有凉皮店均正常营业。公安机关对相关问题正在调查中。

事件回顾
据此前报道,有网传消息称河南永城市 一名20岁左右的女孩与家人在永城市百花街吃了一碗凉皮后中毒 。
7月14日中午,记者联系了当地多家餐饮店了解到,永城市的确要求暂时下架凉皮,停止销售,等待查明原因再通知销售,不过要求暂时停售的是从外面批发的机器制作的凉皮,店里制作,自产自售的并没有受到限制,可以进行售卖。暂时停售的原因,有的店主称“不清楚”;有的店主则称,听说是有人批发凉皮存放时间过长,没有保存好,出了事。
永城市雪枫街道办和永城市市场监督管理局证实, 的确出现中毒事件 ,公安部门已经介入,伤亡情况不掌握。永城市市场监督管理局还表示,该局已经将全市生产凉皮的企业进行了抽检,目前检测正在进行,原因尚不清楚。
7月15日,一名当事家属向媒体表示,他的亲戚小兰(化名)和小兰的舅妈是在7月3日购买的凉皮,吃完后就感觉味道有点不对劲,怀疑变质。第二天早上,小兰舅妈出现问题被送医,小兰则在晚上出现不适症状。经过住院治疗,小兰舅妈依然不幸离世,小兰仍在重症监护室接受救治,情况不容乐观。 医生向家属称,两人是米酵菌酸中毒。

小兰舅妈的检测报告(受访者提供)

小兰的检测报告(受访者提供)
除了这起事件外
让我们先看几个真实的案例

某市一家四口因食用常温放置多天的河粉中毒,其中2人死亡,家中的狗也因食用河粉而中毒死亡。
某地酸汤子中毒事件,其中9人死亡。


某地一女子食用变质黑木耳后中毒身亡。
以上这些事件的幕后黑手就是
我们今天要介绍的主角
↓↓↓
号称“酵米面杀手”的
唐菖蒲伯克霍尔德氏菌
以及它代谢产生的
米酵菌酸毒素
一、什么是唐菖蒲伯克霍尔德氏菌?
1. 唐菖蒲伯克霍尔德氏菌,即椰毒假单胞菌酵米面亚种(1953年,我国学者从黑龙江臭米面食物中毒中分离),是一种革兰氏阴性杆菌,短杆状,无芽孢,有鞭毛。

2. 它在环境中广泛存在,本身并不可怕,煮沸之后就能杀灭,但 其代谢产生的米酵菌酸毒素,极其凶悍 。
3. 米酵菌酸是一种小分子脂肪酸,耐热性极强, 即使经开水煮沸或用高压锅蒸煮也很难被破坏,120℃下加热1小时仍可保持毒性。

二、米酵菌酸中毒有哪些症状?

三、导致米酵菌酸中毒的食品
有哪些?

健康提醒
研究表明,唐菖蒲伯克霍尔德氏菌的最佳产毒温度为26~28℃。 此菌中毒后无特效药,病情的严重程度及预后情况与摄入的毒素量有关 。
眼下广东正是该菌的活跃期,为预防米酵菌酸中毒,在此提醒大家:
受唐菖蒲伯克霍尔德氏菌污染的 河粉、肠粉(卷粉)、陈村粉、粿条、米线(米粉)、濑粉等湿米粉以及泡发或新鲜的银耳、木耳等食品 在高温潮湿天气下容易产生米酵菌酸,米酵菌酸中毒的风险增大。
我国食源性疾病监测结果表明,米酵菌酸中毒导致的死亡是我国微生物性食源性疾病事件的首要死亡原因,中毒死亡率高达40%~100%。
别慌
牢记这几点
四、如何预防米酵菌酸中毒?

五、 发生食物中毒了,该怎么办?
1. 疑似中毒时,请及时就医,并将剩余食物保存好带到医院,以便于医生明确诊断。
2.尽快催吐,排出胃内容物,以减少毒素的吸收和对机体的损伤,同时 告知医生进食史,以便对症治疗 。
3.吃过相同食品未发病的人,也应尽快催吐、洗胃、清肠。

彩蛋环节
这个杀人于无声无息的致病菌,大家难道不感到好奇吗?来,看看。经过疾控人员的细菌培养,唐菖蒲伯克霍尔德氏菌是长这个样子的……
改良马铃薯葡萄糖琼脂(mPDA)
最后提醒大家:
如果怀疑自己中毒了
要尽快催吐
及时就医哦!
(来源:央视新闻、中国新闻网、上观新闻、广东疾控)

出品:科普中央厨房
监制:北京科技报 | 北科传媒
欢迎分享到朋友圈
公众号、报刊等转载
请发邮件至bjkjbeditor@163.com
未经授权谢绝转载,违者必究